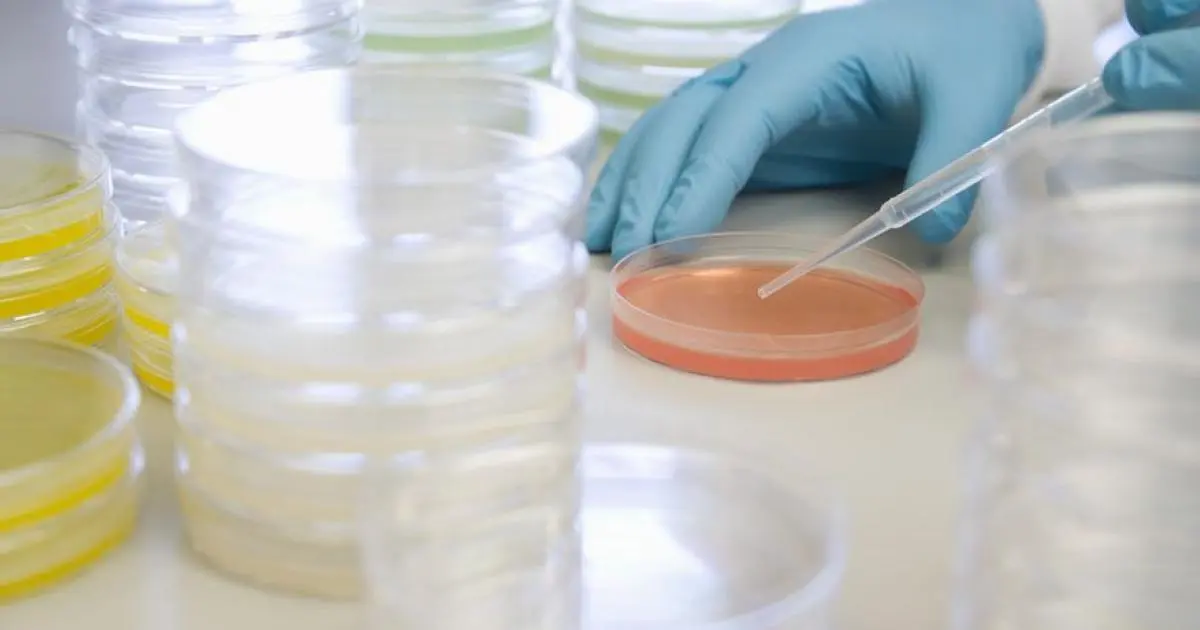

La OMS advierte sobre elevados brotes de cólera globales y escasez de vacunas
Haití, Siria y Malawi están entre los países más afectados, subrayó Tedros, quien advirtió de que estos brotes simultáneos han generado una penuria de vacunas.
2 minutos de lectura
Actualizado: 23 de Julio, 2025, 05:11 PM
Publicado: 11 de Enero, 2023, 11:30 AM
Escuchar el artículo
Compartir:
Ginebra.- El mundo está sufriendo un número sin precedentes de brotes de cólera en países afectados por desastres climáticos y otras crisis, mientras las vacunas para prevenir esta enfermedad se han vuelto "extremadamente escasas", advirtió este miércoles la Organización Mundial de la Salud (OMS).
En 2022 "31 países han reportado brotes, más extendidos y mortales de lo normal y la cifra supone un 50 % más que en años precedentes", alertó en rueda de prensa el director general de la OMS, Tedros Adhanom Ghebreyesus.
Haití, Siria y Malawi están entre los países más afectados, subrayó Tedros, quien advirtió de que estos brotes simultáneos han generado una penuria de vacunas que ha llevado al mecanismo internacional de coordinación de inmunizaciones a tomar la medida de disminuir las dosis administradas a cada paciente (de dos a una)."Pese a esta medida sin precedentes las existencias se mantienen muy bajas y la producción está en su capacidad máxima", lamentó Tedros, quien pidió a los países que hayan sufrido brotes recientemente que aumenten su prevención ante posibles nuevos contagios.

Agencia EFE
La Agencia EFE, o simplemente EFE, es una agencia de noticias internacional con sede en Madrid. Fue fundada en 1939 gracias al impulso del entonces ministro del Interior, Ramón Serrano Suñer, en la que participaron activamente: José Antonio Jiménez Arnau, Manuel Aznar Zubigaray y Vicente Gállego.
Biografía completa »LO MÁS LEÍDO
LO MÁS VISTO
TE PUEDE INTERERSAR